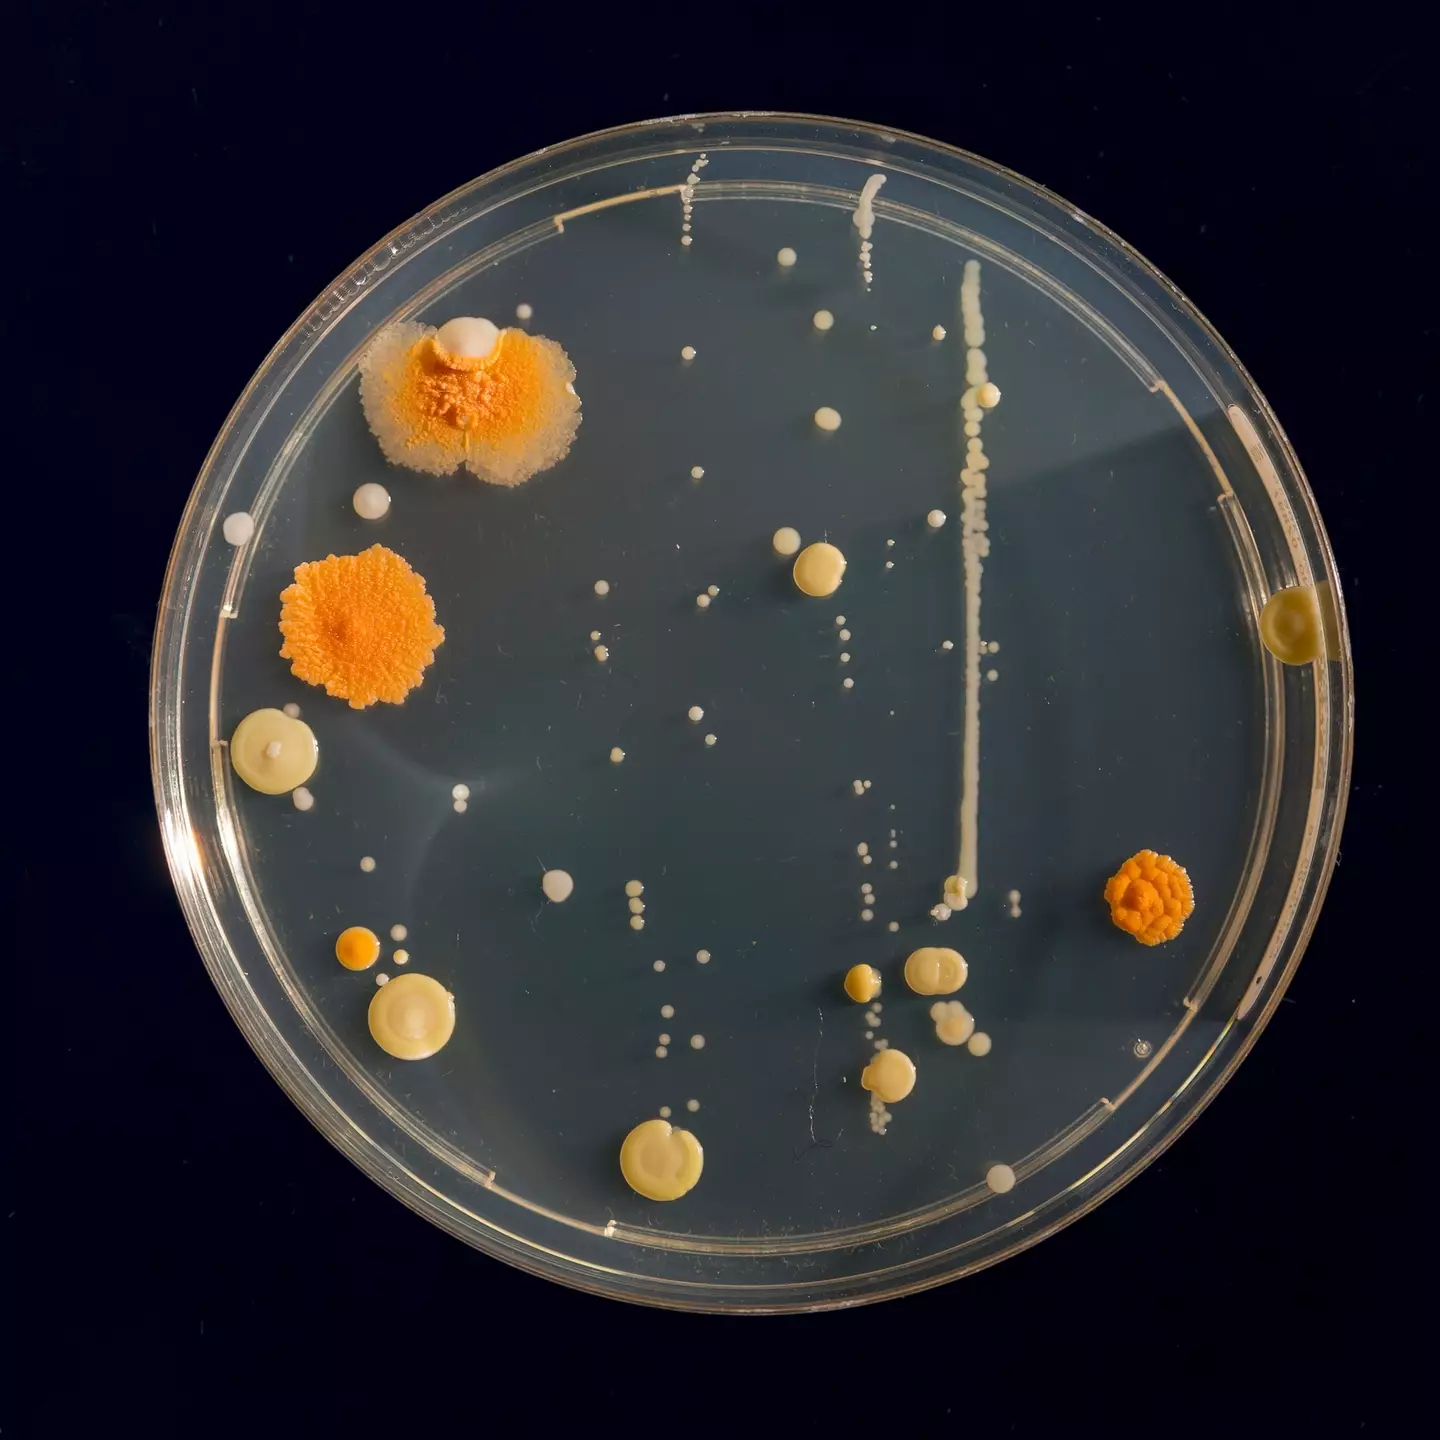
The fungus can live on peoples' skin without causing infection (Getty Stock Images)

A ‘super fungus’ is reported to be quickly spreading across the UK.
Mostly attacking the groin, thighs and bum area, an expert has warned that it’s ‘becoming a really big problem’ here.
Studies say that Trichophyton (T.) indotineae is a ‘newly identified dermatophyte species’ found in a near-epidemic form on the Indian subcontinent.And while infections in the UK were pretty much unheard of here until a few years ago, cases are now rising – reportedly by almost 500 percent in the last three years.
It has been found that T. indotineae accounts for 38 percent of dermatophyte isolates referred to the UK National Mycology Reference Laboratory.And it’s said that many isolates in vitro are resistant to terbinafine – a medicine available on the NHS to treat fungal skin infections – and most infections are clinically resistant to it.

Experts warn it that the ‘super fungus’ is spreading (MDPI)
What is T. indotineae and its symptoms?
T. indotineae infections are said to spread easily from person to person and are classed in studies as an endemic across Asia, with cases also reported worldwide.
Essentially, the fungus is a type of ringworm that has mutated over the years to withstand the standard medicines for fungus.
And so, patients often end up needing months of treatment in hospital with itraconazole. But that drug carries a number of side effects and can cause liver damage or heart problems.
Typically, T. indotineae causes ‘angry’ and ‘formidable’ red itchy rashes, mostly in the groin, thighs and buttocks. If it goes untreated, it can spread to other areas of the body (even the face) and become quite painful, inflamed and vulnerable to infection.
Experts also warn that infection cases can leave sufferers with permanent scarring.
Infectious diseases expert at the University of Manchester, Dr David Denning, added to The Sun: “And it is very socially limiting. Some people won’t feel like they can leave the house or go to work. They can become social pariahs.”
And fungal expert at Imperial College London, Professor Darius Armstrong-James added: “It could be easily mistaken for eczema or psoriasis if tests are not conducted.”

Once infected, it can spread to other parts of the body (MDPI)
Experts’ warnings
The professor also said that T. indotineae infections are ‘becoming a really big problem in the UK’ as he claimed: “We don’t know how endemic, or pandemic, it will get here, but already, the growing frequency of new cases coming into hospitals is very concerning.”
Data recently presented at a conference in Poland revealed that infections in the UK and Ireland have grown from 44 before 2022 to 258 as of March this year.
Dr Denning said it possibly ‘won’t be long’ until it seeps into the wider population, as most cases are currently reported in people of South Asian heritage.
“This is clearly going to become a big issue across the world,” the expert added.Featured Image Credit: MDPI
Here are the symptoms of a potentially deadly fungal virus which is spreading throughout the continent.
Health officials across Europe have raised the alarm after noticing an uptick in cases of infections in hospitals caused by a fungus known as Candidozyma auris (C. auris) – a pathogen that has been recorded on every continent in the world, excluding Antarctica.
According to recent statistics, there has been 134 new cases of C. auris in the UK between November 2024 to April 2025, which is a 23 percent increase compared with the previous six months, according to UKHSA.
So what is the the fungal virus – and how dangerous is it?
Candidozyma auris explained
C. auris is a member of the yeast family. A recently discovered pathogen, it was first identified in a patient in Japan back in 2009.
The fungus can live on peoples’ skin without causing infection (Getty Stock Images)
Infections from the fungus have since been identified in over 40 countries worldwide.
The fungus primarily lives on the skin without causing symptoms, only becoming a problem if it enters into the body.
According to UKHSA, the fungus spreads through contact with contaminated surfaces, medical equipment or transmission from individuals who have the fungus present on their skin, called colonisation.
C. auris is said to thrive in hospitals, can survive on surfaces for weeks and is resist multiple treatments.
What are the symptoms of Candidozyma auris?
Symptoms associated with C. auris often vary, depending on the severity of the infection.
People carrying the fungus on their skin can often be unaware of colonisation. However, other patients can develop much more serious infections, in areas such as: the blood, brain, spinal cord, bones, abdomen, wounds, ears, respiratory tract, and urinary system.
So not quite a The Last of Us apocalyptic scenario, but something for healthcare workers to be concerned about.

Infections are more prevalent in hospitals (Getty Stock Images)
Who is most at risk of Candidozyma auris?
People particularly susceptible to developing severe symptoms from C. auris infections are those with weakened immune systems, particularly those who’ve been in intensive care, hospitalised for an extended period of time or those on courses of antibiotics.
Methods to prevent the spread of C. auris include increasing awareness of hand hygiene, ‘appropriate management’ of patients and effective decontamination of medical equipment.
There are also concerns about the virus becoming resistant to anti-fungal medications, with the UKSHA adding: “C. auris represents a growing global health concern, particularly in healthcare settings where it can spread rapidly and resist treatment and some disinfectants. While not yet widespread in England, it is important that we remain aware that C. auris may spread in hospital environments.
“Through effective infection prevention and control measures, rigorous hygiene practices, ongoing monitoring and continued research, its spread can be minimised.”Featured Image Credit: (Getty Stock Images)
Winter is fast approaching and with it comes the colds and illnesses that are common as temperatures drop.
Unfortunately, that also means that Covid is likely to become more prevalent once again, with two new variants spreading quickly throughout the world.
Thanks to vaccines, we’re unlikely to see another national lockdown anytime soon but health officials are warning people to be wary of both variants of the disease.
After first being identified in Southeast Asia and China in the summer, the XFG.3 strain, known as ‘Stratus’, and NB.1.8.1 strain, known as ‘Nimbus’, are now the most common Covid variants in the UK, according to the UK Health Security Agency (UKHSA).
Although it has been suggested that the two are only likely to cause minor illnesses, the World Health Organisation is keen to monitor both as they have quickly spread across the world into Europe and the US.

Covid cases are on the rise (Getty Stock Image)
While Covid tests and social distancing are a distant memory, much like when you have any sort of illness or bug, it is recommended that you stay at home and avoid contact with others if you do come down with the disease.
The UKHSA is also urging people to book a Covid vaccine, especially those over the age of 75 or those who are immunosuppressed, as they are eligible for a free jab from the NHS.
It said: “It’s normal for viruses to mutate and change, and as more data becomes available on these variants, we’ll have a better understanding of how they interact with our immune systems and how to optimise our protection, as well as actions we can take to keep the most vulnerable safe and live our lives as normally as possible.
“The most important thing is for those eligible to get their vaccination when it is due.”
What are the symptoms of Stratus?
Both strains still possess many of the symptoms we associate with Covid, including shortness of breath, chest tightness, sore or scratchy throat, headaches, body aches, upset stomach, nausea, and loss of taste or smell.
However, those suffering with Stratus have reported a persistent dry cough, tiredness and a fever.

Both variants come with a particularly painful sore throat (Getty Stock Image)
Scientists have also claimed that Stratus appears to be better at evading the immune system, meaning it might be a bit harder to shake off, even if you’re eating fruits and superfoods on a regular basis.
What are the symptoms of Nimbus?
Not to be confused with Harry Potter’s broomstick, the Nimbus Covid variant is leading some folks to experience a particularly painful sore throat, which has been compared to ‘swallowing razor blades‘.
As well as the usual Covid symptoms, Nimbus also often leads to a hoarse voice, which can be helped with some honey, according to the NHS.
With cases on the rise, it’s definitely worth remembering some of the habits we adopted during the pandemic as a way to stay safe this winter.
